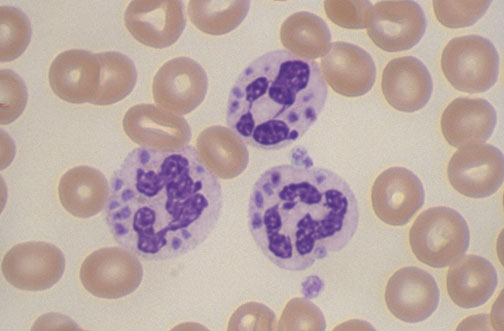

| A history of recurrent bacterial infections and giant granules seen in peripheral blood leukocytes is characteristic for Chediak-Higashi syndrome. This disorder results from a mutation in the LYST gene on chromosome 1q42 that encodes a protein involved in intracecellular trafficking of proteins. Microtubules fail to form properly, and the neutrophils do not respond to chemotactic stimuli. Giant lysosomal granules fail to function. Soft tissue abscesses with Staphylococcus aureus are common. Other cells affected by this disorder include platelets (bleeding), melanocytes (albinism), Schwann cells (neuropathy), NK and cytotoxic T cells (aggressive lymphoproliferative disorder). |
![]() |